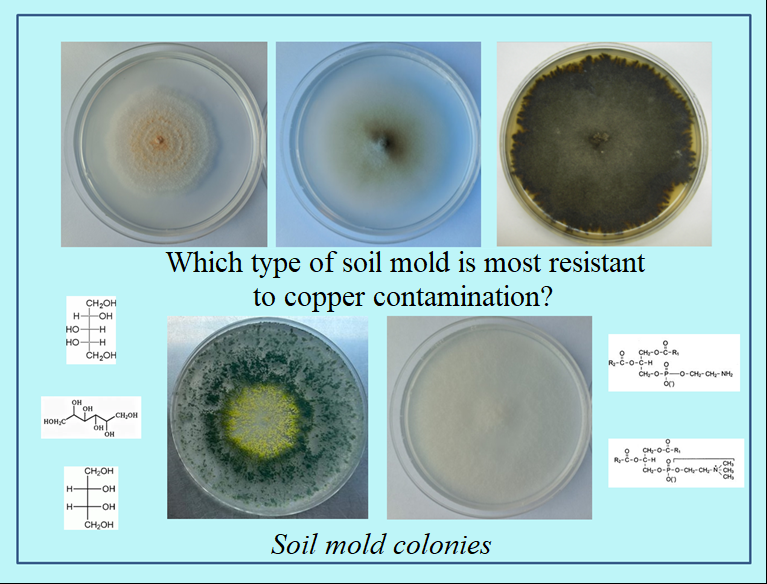

Soil pollution harms flora and fauna. Heavy metals, such as copper, lead, and zinc, are among the most common soil pollutants. Molds, or soil filamentous fungi, seemingly less noticeable but numerous and important soil inhabitants, also encounter these metals in the soil. Molds are considered resilient organisms: they can withstand high levels of pollution and even cleanse soil of heavy metals. However, does this mean that all molds are immune to heavy metals?
To address this, a study was conducted at the A.N. Severtsov Institute of Ecology and Evolution of the Russian Academy of Sciences (IEE RAS), together with colleagues from the S.N. Vinogradsky Institute of Microbiology of the Russian Academy of Sciences. The study examined the effect of copper on important biological molecules of several molds—lipids and osmolytes. Lipids are fat-like substances that play a crucial role in the structure and functioning of living organisms. Lipids are part of the main protective barrier of any cell – the cell membrane. Osmolytes are responsible for the stability of living organisms, despite changing external conditions and stress.
The study showed that copper causes changes in the composition of these biological molecules. This helps us understand how molds resist the effects of heavy metals and which fungal species are more successful in this resistance. Therefore, molds can hardly be considered invulnerable to heavy metals.
The results of the study were published in the international journal BioMetal (Q1; IF 4.1): Elena V. Fedoseeva, Vera M. Tereshina, Olga A. Danilova, Elena A. Ianutsevich, Anna E. Ivanova, Vera A. Terekhova. Biochemical responses of soil filamentous fungi to copper: changes in lipid and osmolyte composition. Biometals (2025).